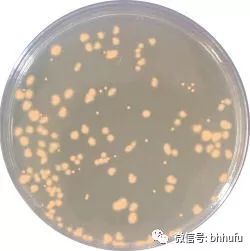

多年来,化妆品业界流行“无添加化妆品”,甚至曾有品牌打出广告称“我们恨化学”,引起了媒体的热议。

这当然是一件非常尴尬的事情:开发化妆品的工程师一般毕业于精细化工或应用化学专业,他们所使用的所有原料都是化学物质,我们——人类——本质上也是化学物质的有机构成。然而。。。。我们恨化学。。这个脑弯我是转不过来的。
当然,无添加化妆品尚没有这么极端,它又是怎么发生的呢?我们又该如何看待防腐剂和香精呢?
一、为什么会有无添加化妆品?
无添加化妆品通常是指不添加香精和人工防腐剂的化妆品,当然有厂商把它进一步扩展为“无添加酒精”、“无添加矿物油”等,在业界,无添加还没有一个被公认的定义。不添加香精和防腐剂,是无添加化妆品的基本特点。

催生无添加化妆品的,是人们对于香精和防腐剂的恐惧。确实,随着现代化妆品工业的发达,化妆品造成的皮肤问题也很常见,尤其是接触性皮炎(刺激或者过敏)。一项美国为期64个月(1977-1983)的大规模研究结果表明,化妆品中最常见的致敏成分是香精和防腐剂,由于其应用规模非常大,因此甚至超过了著名的对苯二胺(当然,对苯二胺使用时只是不小心才会接触到头皮)。这项研究的化妆品致敏成分排名是:香料香精>防腐剂>对苯二胺(染发剂)>羊毛脂及其衍生物>巯基乙酸酯(用于烫发和脱发)和丙二醇(用于保湿)。
防腐剂的致敏性中,季铵盐-15>咪唑烷基脲>尼泊金酯类(Parabens,对羟基苯甲酸)>2-溴-2-硝基-1,3-丙二醇(布罗波尔, BNP)>甲醛。
随着敏感性皮肤的不断增多,人们越来越期望拥有更加安全、低刺激、低致敏性的护肤品,这是催生无添加化妆品的直接动力。
二、防腐剂和香精的今生前世
最早,化妆品并不具备太多的功效,就护肤而言,古时候人们顶多用点动物、植物油来缓解皮肤的干裂,取材天然;后来有了矿物油,又要追求肤感,慢慢有了乳化体,即:水性和油性成分混合。至1970年代Kligman倡导功能性化妆品(又译为药妆),在化妆品中添加的功效性成分越来越多,不仅用于滋润清洁,改变一下颜色和外观,更着眼于维护皮肤本身的健康、平衡,甚至使衰老与不良的皮肤状况得到缓解甚至逆转(参见:什么是药妆品?)。
化妆品的营养越来越丰富,既是皮肤的“食物”,也是细菌、霉菌等微生物的培养基。化妆品在制造、运输、存储、使用过程中,必须保持稳定,不能腐败变质,因此加入防腐成分,就很有必要。
如果不加防腐剂,微生物很可能在化妆品中生长
香精的作用,则主要是感官改善。使用化妆品本身是一种美的享受,如果气味难闻,恐怕也很难有愉悦感,而一些化妆品原料的气味未必讨人喜欢,这时就有必要加入香料改善其味道,甚至某种味道可以成为文化、品牌的体现。最初的香料都来自天然,但因为成本及性能的关系,逐步开发出人工合成香精予以取代或者补充。
三、无添加化妆品的技术路线
如前所述,若要宣称为“无添加化妆品”,则至少不能添加防腐剂和香精。香精的问题比较简单,可以不添加人工合成香精,或者可以用天然精油、具有天然香味的植物性成分(比如一些有香味的中药)取而代之。
防腐剂则复杂得多。因为不添加防腐剂,就很难保证产品的稳定。但是添加吧,又有前面的问题,于是有了不同的技术路线,分别涉及化妆品原料、生产、包装。
(1)原料:最典型的方法是避开法规中列为化妆品防腐剂而限定使用的成分,这在中国目前是56种(见下表),而改用具有防腐作用但不在列表中的其它成分,常用的有:辛甘醇(辛二醇,Octylene Glycol,Octanediol)、戊二醇(Pentylene Glycol,Pantanediol)、己二醇(Hexanediol)等多元醇类,以及对羟基苯乙酮、辛酰羟肟酸等。有些成分通常抗菌谱有限(能抑制的微生物种类不够多),还需要彼此配合,或者跟一些其它的防腐效果促进类成分复配,如柠檬酸。我们可以将其称为“类防腐剂”。

另外,一些天然植物类的成分,不属于防腐剂,也可以达到抑制细菌的效果,例如苦参、黄连/黄柏、丁香、肉桂、芍药、丹皮、黄芩等,这些成分如果达到一定浓度,甚至可以不必添加其它防腐剂。不过植物提取物通常价格比上面的类防腐剂贵好多倍,而且添加量一般也要比较高,并不是很经济,而且有的颜色较深,不能满足产品外观的要求,只有在一些特殊的产品上使用,达到既能护肤,又可防腐的作用。
酒精也有防腐作用。在食品上,酒精含量超过10%的酒精饮料可以不标注有效期,因为很少有什么微生物可以在这种酒精度下存活,同理,如果一些爽肤水中的酒精含量达到15%甚至20%,防腐也会很容易,只是酒精含量如此大,一般不易跻身为“无添加化妆品”。

此外,微生物必须要吸收化妆品中的营养才能存活。你肯定只见过面包发霉,没见过石头腐烂,因为石头里面没有微生物所需要的营养。让化妆品的成分更简单、不使用一些易于被微生物利用的成分(如合成酯、醇类、常见脂肪酸),也是一种路线。换句话说,某些情况下,无添加化妆品可能要以牺牲部分功效性能为代价。
(2)生产过程
如果想在化妆品中不添加类防腐剂,那么就必须保证产品在生产过程中处于非常洁净的环境下,需要使用到类似于医药产品良好生产的规范(GMP)和生产环境、设备。在药品上,注射剂的条件是最严格的,要接近无菌状态(最后还要灭菌)、空气尘埃达到万级以下,这对生产设备、工艺、流程形成挑战,成本也很高昂,这样做的必要性也值得考量。

(3)包装材料
化妆品都有一个较长的运输、存储和使用过程。短则数月,长则经年,包装的材质、形式,对于其稳定性有重大影响。具体到存储和使用阶段的防腐,主要是包材的密闭性。为了避免使用和存储过程中的污染,无添加化妆品多会采用如下包装方式:
小包装:做成很小支/袋,或者胶囊状,只能用一次或者几次,很快用完。例如现今流行的安瓿

真空瓶等真空包装:Aireless pump bottle,可以被认为是一个注射器,瓶子内壁光滑,底部是活动的活塞,当上部泵头泵出化妆品后,活塞在负压作用下推进,这样就避免了外界空气会进入接触化妆品。作为其衍生形式,出现了雅漾“无菌仓”包装,其出口是一个单向阀,化妆品只能挤出而空气不能进入,下部则是一个软管,在负压下可以变扁,这样就省略了活塞,成本也比真空泵低。当然,近年来还出现了双层真空囊袋包装,其原理与真空瓶是一样的。

灭菌:也有部分产品,如果它们本身耐辐射或耐高温的话,可以在产品做成后,或者把原材料用这两种方法灭菌。常见的是钴60辐射灭菌。某些植物类成分,如果耐高温的话,可以用UHT(瞬时超高温灭菌)或者湿热灭菌,这样,产品出厂时是无菌的,也就谈不上需要添加防腐剂的问题了。
四、声称“无矿物油”的意义是否很大?
虽然矿物油并非十全十美,但用于化妆品的精炼矿物油是安全的,致敏性极低。虽然我在心理上倾向于使用仿生剂和某些天然植物油来滋润并促进皮肤健康,但矿物油也没有什么不妥。我个人不觉得有宣传“无矿物油”的必要,如果真的是没有用矿物油,可代之以“使用天然营养油脂”,而不必特别贬低矿物油(关于矿物油的安全性等,将专文另行讨论 )。
另外,也不排除一些厂商虽然不使用矿物油(液体石蜡、凡士林),但使用合成酯/脂类,有一些也并不见得比矿物油更好,例如一些明确地、具有致粉刺性的酯类。
五、无添加化妆品到底有没有实际的意义?
从一定程度上来讲,无添加化妆品有其意义,特别是针对敏感性皮肤时,一些成分如香精、酒精容易引起刺激或过敏。而防腐剂,也可以尽可能减少不良反应发生的机率(敏感性皮肤,请参见:过度护肤,敏感性皮肤第一大杀手)。
但是,我们是否应当要对“有添加”了防腐剂的产品那么不屑一顾甚至情有敌意呢?这是不尽然的。
一方面,使用合适的防腐剂可以减少成本,从而能够让人们能以合适的价格买到可用化妆品。可以讲,如果没有防腐剂的存在,现代化妆品工业无法正常发展。
另一方面,可以对防腐体系进行优化,甚至开发新型的防腐成分,它们更加温和、不刺激。从前文所列举的研究结果我们可以发现,有些安全性欠佳的防腐成分是历史上曾经时兴的,现今已经不是很流行了,特别是一些甲醛释放型防腐剂。
还应当看到,针对不同的产品类型,可以使用不同的防腐剂。在淋洗型产品,比如洗发香波、沐浴露中,防腐剂很快就会被冲掉,一般不会引起什么安全性问题,所以即使使用甲醛释放型防腐剂问题也不大;而在驻留型产品,特别是像面膜这类带有促渗功能的,就必须慎之又慎了,苯氧乙醇、甲基异噻唑啉酮之类的防腐成分使用就要十分小心。
这些成分是否会引起不良反应,与每个人的个体情况也有关,比如皮肤受损情况下,酒精之类的成分浓度到一定水平,可能容易引发刺激感,但正常皮肤的没有问题。而过敏,则完全与每个人的免疫系统特点有关,如果你使用的那些防腐成分并没有造成你的不良反应,那就不必担心,放心用就是了。也就是说:正常情况下,我们未必一定要追求未添加香精、防腐剂的护肤品。
防腐剂一直是业界的热点问题,许多研究人员和公司都在追求更安全、更温和、更有效的防腐体系,近些年来也有一些新的体系问世;配方师们近年来对此问题也十分关注,就我所见到的情况,越来越多的厂家开始使用更温和和安全的防腐体系,这都是十分好的趋势,也是消费者之福。
总结起来一句话:敏感性皮肤,无添加化妆品有一定意义;正常皮肤、痘痘、玫瑰痤疮、脂溢性皮炎等皮肤,未必要追求无添加。
版权声明:CosMeDna所有作品(图文、音视频)均由用户自行上传分享,仅供网友学习交流。若您的权利被侵害,请联系删除!
本文链接://www.cosmedna.com/article/621926269.html


































